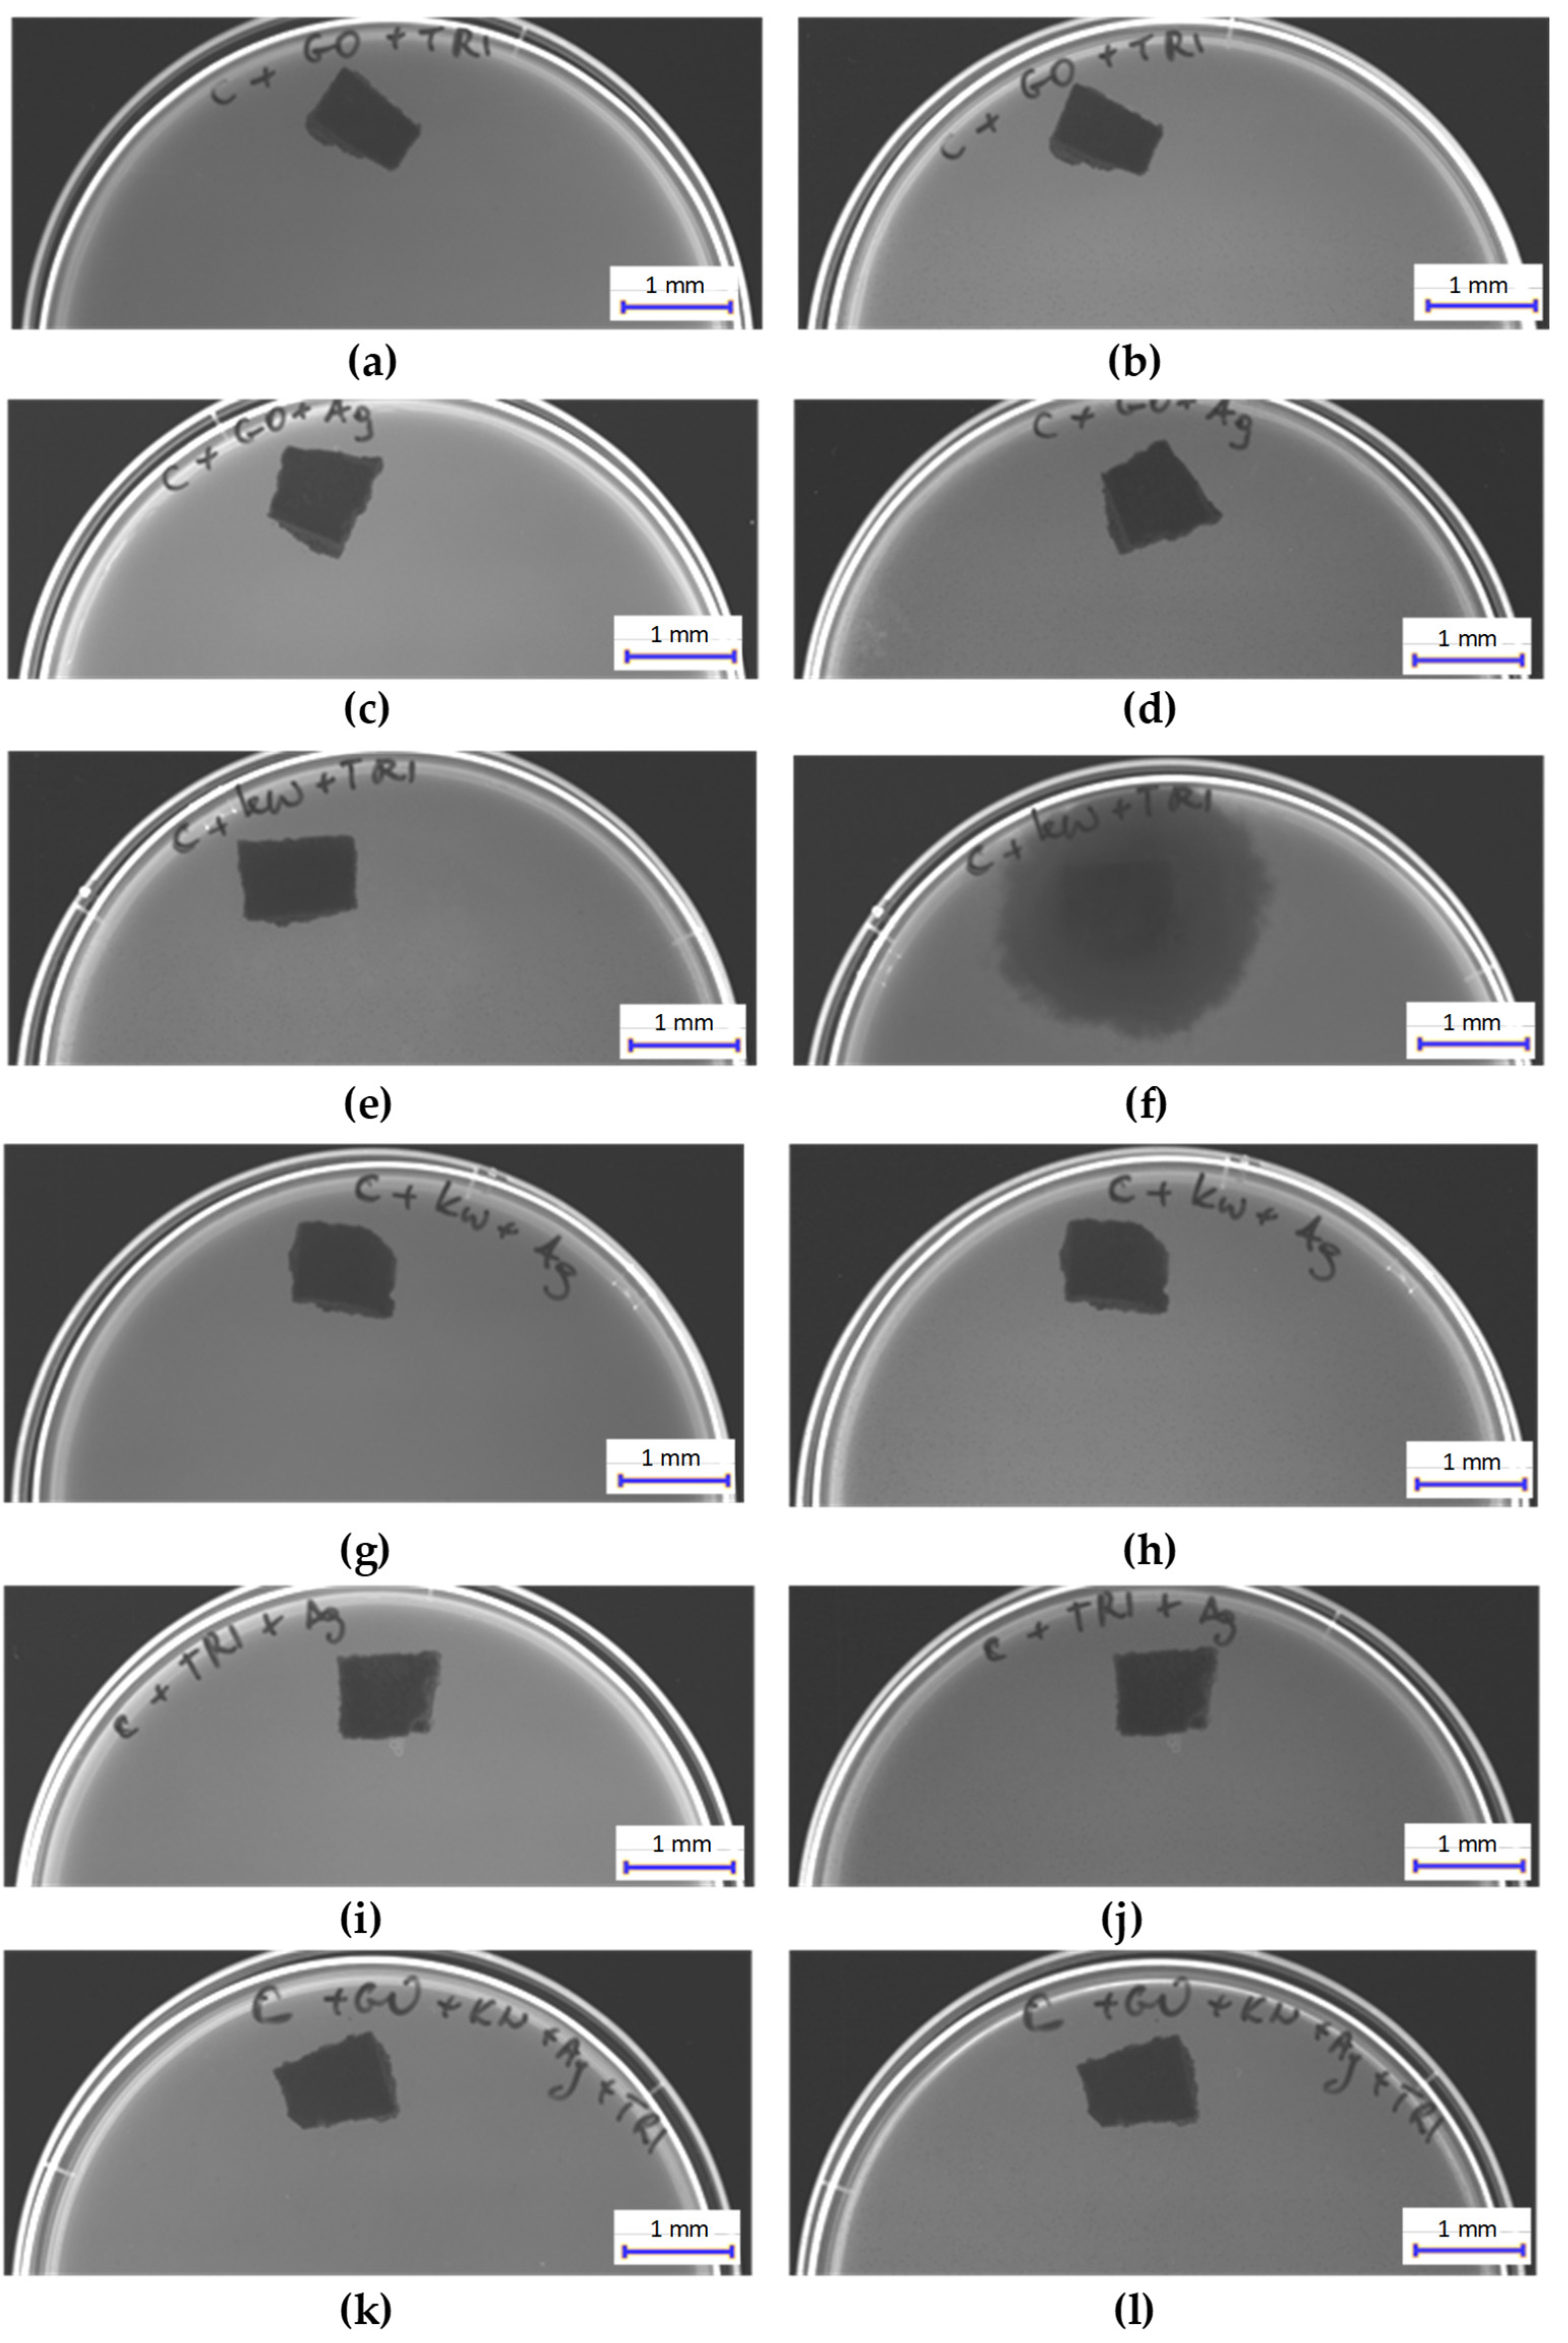
Materials 17 06288 g012 Materials 17 06288 g012

Effect of Doping Cement Mortar with Triclosan, Hypochlorous Acid, Silver Nanoparticles and Graphene Oxide on Its Mechanical and Biological Properties
Abstract
1. Introduction
2. Materials and Methods
2.1. Method of Making Cement Mortar
2.2. Research Methods
2.2.1. Structural Testing of Surfaces
- Stereoscopic microscope:Structure imaging of cement mortar, doped with triclosan (C + Tr, C + GO +Tr, C + HClO + Tr, C + Tr + Ag and C + GO + HClO+ Tr + Ag), hypochlorous acid (C + HClO, C + HClO*, C + GO + HClO, C + HClO + Tr, C + HClO + Ag, C + Tr + Ag and C + GO + HClO+ Tr + Ag), silver nanoparticles (C + Ag, C + GO + HClO, C + GO + Ag, C + HClO + Ag, C + Tr + Ag and C + GO + HClO+ Tr + Ag) and graphene oxide (C + GO, C + GO + HClO, C + GO +Tr, C + GO + Ag and C + GO + HClO+ Tr + Ag) was performed using a Zeiss SmartZoom 5 steerable microscope (Carl Zeiss Meditec AG (Headquarter) Göschwitzer, Jena, Germany). A PlanApo D 1.6/0.1 FWD 36 mm objective was used.
- Contact angle:The contact angle was measured using an optical microscope (6000 VHX, Keyence Corporation, Osaka, Japan). Droplets of ultrapure water with a volume of about 3 µL from a constant height of 5 mm were dropped onto the surface of a laboratory slide with C, C + GO, C + HClO, C + HClO*, C + Tr, C + Ag, C + GO + HClO, C + GO +Tr, C + GO + Ag, C + HClO + Tr, C + HClO + Ag, C + Tr + Ag and C + GO + HClO+ Tr + Ag.
- Fourier-transform Infrared Spectroscopy (FTIR) study of the chemical surface composition:Samples listed in Table 1 were analyzed by FTIR (Nicolet IS50, FTIR, ThermoFisher SCIENTIFIC, Waltham, MA, USA) using ATR mode in a range of 400–4000 cm−1 with a resolution of 4 cm−1 and 64 scans.
- Reflectance:Reflectance measurements were carried out on a Lambda 900 spectrometer from Perkin Elmer (Waltham, MA, USA), equipped with a PELA 1001 Downward Viewing integration sphere from Labsphere (North Sutton, NH, USA), which allows measurement of total reflectance, diffuse reflectance and determination of specular reflectance. Total reflectance values were determined in the spectral range 250–2500 nm with a measurement step of 1 nm. The measurement results are the dependence of the total reflectance R [%] on the wavelength λ [nm].
2.2.2. Tests of Mechanical Properties
2.2.3. Biological Research
- Analysis of bacterial inhibition zones:Analysis of bacterial growth and its inhibition after exposure to cement mortar was prepared with two bacterial strains: Staphylococcus aureus (ATCC 25923) and Pseudomonas aeruginosa (ATCC 27853), which were obtained from the American Type Culture Collection (ATCC) and they were maintained in 20% (v/v) glycerol at −20 °C. On the surface of solidified Mueller–Hinton agar prepared in Petri dishes (Ø90 mm), the spread plate method of bacterial suspension (0.5 on the McFarland scale) was performed, and then the samples of cement mortar (10 × 10 mm) were placed on the surface. The plates were incubated in standard conditions (24 h, 37 °C). After incubation, the inhibition zones were measured and captured with an Azure C400 (Azure Biosystem, Dublin, CA, USA). The procedure of preparing samples to this analysis was described in [14].
- Bacterial viability analysis:Bacterial viability of two tested bacteria species (S. aureus and P. aeruginosa) exposed to cement mortar was analyzed using an XTT Cell Proliferation Kit II (cat no. 11465015001, Merck, Darmstadt, Germany). Samples were placed in the wells of a 24-well plate, in which 1 mL of Mueller–Hinton broth (Biomaxima, Lublin, Poland) was added and each well was inoculated with 10 µL bacteria suspensions (1.5 × 108 cells/mL). After 24 h of incubation (37 °C), XTT reagent was added and after 30 min, absorbance with an excitation wavelength of 450 nm and emission of 690 nm was measured. The results are presented as a viability % relative to the control. The procedure of preparing samples to this analysis was described in [14].
- Fungi growth analysis:The analysis of samples listed in Table 1 on the growth of fungi from the genus Fusarium was performed. For this purpose, cement mortar samples were soaked with fungi spores suspension (106 cells/mL) and prepared samples were placed onto Sabouard agar (Biomaxima, Lublin, Poland). Plates were incubated (25 °C) for 7 and 14 days. Fungi growth was measured and captured with an Azure C400 camera (Azure Biosystem, Dublin, CA, USA).
3. Results
3.1. Structural Research
3.1.1. Stereoscopic Microscope
3.1.2. Contact Angle
3.1.3. FTIR
3.1.4. Total Reflection—Reflectance
3.2. Testing the Flexural and Compressive Strength of Cement Mortar Beams
3.3. Badania Biologiczne Biological Studies
3.3.1. Results of Bacterial Growth Inhibition Tests
3.3.2. Results of Bacterial Viability Tests
3.3.3. Results of Fungal Growth Inhibition Tests
4. Discussion
5. Conclusions
- The smallest amount of micropores was observed on the surface of the C + HClO and C + HClO + Tr samples, suggesting that these of additives may improve the density of the cement mortar structure.
- FTIR spectroscopy studies showed that most of the prepared samples (C, C + Ag, C + Tr, C + GO + HClO, C + HClO*, C + GO + Tr, C + GO + Ag, C + HClO, C + HClO + Tr) did not have additional peaks indicating structural changes due to the addition of additives. Similarly, reflectance spectra did not show additional peaks associated with such changes, and the results were similar to the control samples (C, C + GO, C + HClO, C + Tr, C + HClO*, C + GO + HClO, C + Tr + GO, C + GO + Ag, C + HClO + Tr, C + HClO + Ag, C + Tr + Ag, C + GO + HClO + Tr + Ag). This means that the additives did not significantly affect the chemical structure of the material, and changes in its mechanical and biological properties may result from other mechanisms.
- An increase in strength was observed for the samples doped with hypochlorous acid (C + HClO) and graphene oxide with hypochlorous acid (C + GO + HClO). The flexural strength with a single-point load and compressive strength increased by 18.2–29% compared to the control samples. The increase in strength may be due to the filling of micropores and improvement of the internal structure of the cement mortar thanks to the additives.
- The greatest inhibition of Staphylococcus aureus growth was observed in the C + HClO + Ag sample, while for Pseudomonas aeruginosa, the C + HClO and C + HClO + Tr samples exhibited the best results. This suggests that the combination of hypochlorous acid and silver has particularly strong antibacterial activity.
- The lowest viability of Staphylococcus aureus was observed for the C + Tr sample, while for Pseudomonas aeruginosa, the C + GO + Ag sample showed the most significant reduction. This result indicates a higher effectiveness of these additives against Gram-negative bacteria, especially due to the synergistic effect of silver and graphene oxide.
- A complete inhibition of fungal growth was observed in most samples, specifically C + Ag, C + Tr, C + GO + HClO, C + GO + Tr, C + GO + Ag, C + HClO + Ag, C + Tr + Ag, C + GO + HClO + Tr + Ag. This indicates that the addition of silver, triclosan, and graphene oxide is effective in combating fungi, which is important for preventing their growth in damp building conditions.
6. Patents
Author Contributions
Funding
Institutional Review Board Statement
Informed Consent Statement
Data Availability Statement
Conflicts of Interest
References
- Yin, W.; Xu, S.Y.; Wang, Y.T.; Zhang, Y.L.; Chou, S.H.; Galperin, M.Y.; He, J. Ways to control harmful biofilms: Prevention, inhibition, and eradication. Crit. Rev. Microbiol. 2021, 47, 57–78. [Google Scholar] [CrossRef] [PubMed]
- Baumler, W.; Eckl, D.; Holzmann, T.; Schneider-Brachert, W. Antimicrobial coatings for environmental surfaces in hospitals: A potentialnew pillar for prevention strategies in hygiene. Crit. Rev. Microbiol. 2022, 48, 531–564. [Google Scholar] [CrossRef] [PubMed]
- Ledwoch, K.; Dancer, S.J.; Otter, J.A.; Kerr, K.; Roposte, D.; Maillard, J.Y. How dirty is your QWERTY? The risk of healthcarepathogen transmission from computer keyboards. J. Hosp. Infect. 2021, 112, 31–36. [Google Scholar] [CrossRef] [PubMed]
- Ledwoch, K.; Dancer, S.J.; Otter, J.A.; Kerr, K.; Roposte, D.; Rushton, L.; Weiser, R.; Mahenthiralingam, E.; Muir, D.D.; Maillard, J.Y. Beware biofilm! Dry biofilms containing bacterial patho-gens on multiple healthcare surfaces; a multi-centre study. J. Hosp. Infect. 2018, 100, e47–e56. [Google Scholar] [CrossRef]
- Parente, J.M.; Santos, P.; Valvez, S.; Silva, M.P.; Reis, P.N.B. Fatigue behaviour of graphene composites: An overview. Procedia Struct. Integr. 2020, 25, 282–293. [Google Scholar] [CrossRef]
- Demir, K.; Gavgali, E.; Yetim, A.F.; Akpinar, S. The effects of nanostructure additive on fracture strength in adhesively bonded joints subjected to fully reversed four-point bending fatigue load. Int. J. Adhes. Adhes. 2021, 110, 102943. [Google Scholar] [CrossRef]
- Rafiee, M.A.; Rafiee, J.; Srivastava, I.; Wang, Z.; Song, H.; Yu, Z.-Z.; Koratkar, N. Fracture and fatigue in graphene nanocomposites. Small 2010, 6, 179–183. [Google Scholar] [CrossRef]
- Li, L.; Zheng, Q.; Han, B.; Ou, J. Fatigue behaviors of graphene reinforcing concrete composites under compression. Int. J. Fatigue 2021, 151, 106354. [Google Scholar] [CrossRef]
- Yavari, F.; Rafiee, M.A.; Rafiee, J.; Yu, Z.-Z.; Koratkar, N. Dramatic Increase in Fatigue Life in Hierarchical Graphene Composites. ACS Appl. Mater. Interfaces 2010, 2, 2738–2743. [Google Scholar] [CrossRef]
- Liu, L.; Zhang, J.; Zhao, J.; Liu, F. Mechanical properties of graphene oxides. Nanoscale 2012, 4, 5910–5916. [Google Scholar] [CrossRef]
- Zeng, H.; Zhou, R.; Yu, J.; Hu, Y.; Qu, S.; Chen, J.; Hou, S. Experiment and modelling of degradation mechanism of cement mortar with graphene oxide nanosheets under sulfate attack. Cem. Concr. Compos. 2025, 155, 105833. [Google Scholar] [CrossRef]
- Singh, N.; Sharma, V.; Kapoor, K. Graphene in construction: Enhancing concrete and mortar properties for a sustainable future. Innov. Infrastruct. Solut. 2024, 9, 428. [Google Scholar] [CrossRef]
- Liao, C.; Lin, B.; Li, M.; Hu, S.; Dai, G.; Liu, D.; Huang, S. Study on the properties of graphene oxide cementitious grout materials and its cementing effect in reinforcing broken rock mass by grouting. J. Build. Eng. 2024, 961, 110458. [Google Scholar] [CrossRef]
- Compton, O.C.; Nguyen, S.B.T. Graphene Oxide, Highly Reduced Graphene Oxide, and Graphene: Versatile Building Blocks for Carbon-Based Materials. Nano Micro Small 2010, 6, 711–723. [Google Scholar] [CrossRef]
- Dikin, D.A.; Stankovich, S.; Zimney, E.J.; Piner, R.D.; Dommett, G.H.B.; Evmenenko, G.; Nguyen, S.T.; Ruoff, R.S. Preparation and characterization of graphene oxide paper. Nature 2007, 448, 457–460. [Google Scholar] [CrossRef]
- Park, S.; Lee, K.; Bozoklu, G.; Cai, W.; Nguyen, S.T.; Ruoff, R.S. Graphene Oxide Papers Modified by Divalent Ions—Enhancing Mechanical Properties via Chemical Cross-Linking. ACS Nano 2008, 2, 572–578. [Google Scholar] [CrossRef]
- Nasiłowska, B.; Bombalska, A.; Kutwin, M.; Lange, A.; Jaworski, S.; Narojczyk, K.; Olkowicz, K.; Bogdanowicz, Z. Ciprofloxacin, Cefazolin-, and Methicilin-Soaked Graphene Paper as an Antibacterial MediumSuppressing Cell Growth. Int. J. Mol. Sci. 2024, 25, 2684. [Google Scholar] [CrossRef]
- Zielińska-Górska, M.; Sosnowska-Ławnicka, M.; Jaworski, S.; Lange, A.; Daniluk, K.; Nasiłowska, B.; Bartosewicz, B.; Chwalibog, A.; Sawosz, E. Silver Nanoparticles and Graphene Oxide Complex as an Anti-Inflammatory Biocompatible Liquid Nano-Dressing for Skin Infected with Staphylococcus aureus. J. Inflamm. Res. 2023, 16, 5477–5493. [Google Scholar] [CrossRef]
- Sowińska, A.; Lange, A.; Kutwin, M.; Jaworski, S.; Skrzeczanowski, W.; Bombalska, A.; Romiszewska, A.; Olkowicz, K.; Bogdanowicz, Z.; Nasiłowska, B. Effect of Graphene Aerosol Doped with Hypochlorous Acid, Curcumin, and Silver Nanoparticles on Selected Structural and Biological Properties. Materials 2024, 17, 5640. [Google Scholar] [CrossRef]
- Nasiłowska, B.; Włodarski, M.; Kaliszewski, M.; Bogdanowicz, Z.; Krzowski, Ł.; Kopczyński, K.; Witkowski, G.; Czeczott-Urban, A.; Bombalska, A.; Urbańska, M.; et al. Decontamination Effect of Hypochlorous Acid Dry Mist on Selected Bacteria, Viruses, Spores, and Fungi as Well as on Components of Electronic Systems. Int. J. Mol. Sci. 2024, 25, 7198. [Google Scholar] [CrossRef]
- Villalaín, J.; Mateo, C.R.; Aranda, F.J.; Shapiro, S.; Micol, V. Membranotropic Effects of the Antibacterial Agent Triclosan. Arch. Biochem. Biophys. 2001, 390, 128–136. [Google Scholar] [CrossRef] [PubMed]
- Nudera, W.J.; Fayad, M.I.; Johnson, B.R.; Zhu, M.; Wenckus, C.S.; Begole, E.A.; Wu, C.D. Antimicrobial effect of triclosan and triclosan with Gantrez on five common endodontic pathogens. J. Endod. 2007, 33, 1239–1242. [Google Scholar] [CrossRef] [PubMed]
- Yazdankhah, S.P.; Scheie, A.A.; Høiby, E.A.; Lunestad, B.T.; Heir, E.; Fotland, T.Ø.; Naterstad, K.; Kruse, H. Triclosan and antimicrobial resistance in bacteria: An overview. Microb. Drug Resist. 2006, 12, 83–90. [Google Scholar] [CrossRef] [PubMed]
- BS EN 12390-2:2009; Testing Hardened Concrete. Making and Curing Specimens for Strength Tests. The British Standards Institution: London, UK, 2009.
- BS EN 12390-3:2009; Testing Hardened Concrete. Compressive Strength of Test Specimens. The British Standards Institution: London, UK, 2009.
- BS EN 12390-5:2019; Testing Hardened Concrete Flexural Strength of Test Specimens. The British Standards Institution: London, UK, 2019.
- Sinicropi, M.S.; Iacopetta, D.; Ceramella, J.; Catalano, A.; Mariconda, A.; Pellegrino, M.; Saturnino, C.; Longo, P.; Aquaro, S. Triclosan: A Small Molecule with Controversial Roles. Antibiotics 2022, 11, 735. [Google Scholar] [CrossRef]
- Welsch, T.T.; Gillock, E.T. Triclosan-resistant bacteria isolated from feedlot and residential soils. J. Environ. Sci. Health A Tox Hazard. Subst. Environ. Eng. 2011, 46, 436–440. [Google Scholar] [CrossRef]
- Trusek, A.; Kijak, E.; Granicka, L. Graphene oxide as a potential drug carrier–Chemical carrier activation, drug attachment and its enzymatic controlled release. Mater. Sci. Eng. C 2020, 116, 111240. [Google Scholar] [CrossRef]
- Sanchez, J.A.; Materon, L.; Parsons, J.G.; Alcoutlabi, M. Synthesis, Characterization, and Antibacterial Activity of Graphene Oxide/Zinc Hydroxide Nanocomposites. Appl. Sci. 2024, 14, 6274. [Google Scholar] [CrossRef]
- Yin, I.X.; Zhang, J.; Zhao, I.S.; Mei, M.L.; Li, Q.; Chu, C.H. The Antibacterial Mechanism of Silver Nanoparticles and Its Application in Dentistry. Int. J. Nanomed. 2020, 15, 2555–2562. [Google Scholar] [CrossRef]
- Jian, Y.; Chen, X.; Ahmed, T.; Shang, Q.; Zhang, S.; Ma, Z.; Yin, Y. Toxicity and action mechanisms of silver nanoparticles against the mycotoxin-producing fungus Fusarium graminearum. J. Adv. Res. 2022, 38, 1–12. [Google Scholar] [CrossRef]
- Wójcik, A. Microbiological hazard in buildings based on the example of dwelling houses and public utility buildings in Warsaw. Folia Biol. Oecologica 2014, 10, 101–106. [Google Scholar] [CrossRef][Green Version]
- Wolny-Koładka, K. Grzyby z rodzaju fusarium—Występowanie, charakterystyka iznaczenie w środowisku. Kosmos 2014, 63, 623–633. [Google Scholar]

| Lp. | Sample Determination | Composition of the Mixture |
|---|---|---|
| 1 | C | Control as cement mortar |
| 2 | C + GO | 1 kg cement mortar + graphene oxide (concentration 4.5 g/L, 2.75 mL added) |
| 3 | C + HClO | 1 kg cement mortar + hypochlorous acid (concentration 2000 ppm, 12.8 mL added) |
| 4 | C + HClO* | 1 kg cement mortar with hypochlorous acid (no water added) (concentration 2000 ppm) |
| 5 | C + Tr | 1 kg cement mortar + triclosan (concentration 0.0108 g/L, 0.5 mL added) |
| 6 | C + Ag | 1 kg cement mortar + silver nanoparticles (concentration 100 mg/L, 63 mL added) |
| 7 | C + GO + HClO | 1 kg cement mortar + graphene oxide (concentration 4.5 g/L, 2.75 mL added) + hypochlorous acid (concentration 2000 ppm, 25.6 mL added) |
| 8 | C + GO +Tr | 1 kg cement mortar + graphene oxide (concentration 4.5 g/L, 2.75 mL added) + triclosan (concentration 0.0108 g/L, 0.5 mL added) |
| 9 | C + GO + Ag | 1 kg cement mortar + graphene oxide (concentration 4.5 g/L, 2.75 mL added) + silver nanoparticles (concentration 100 mg/L, 63 mL added) |
| 10 | C + HClO + Tr | 1 kg cement mortar + hypochlorous acid (concentration 2000 ppm, 12,8 mL added) + triclosan (concentration 0.0108 g/L, 0.5 mL added) |
| 11 | C + HClO + Ag | 1 kg cement mortar + hypochlorous acid (concentration 2000 ppm, 12.8 mL added) + silver nanoparticles (concentration 100 mg/l.63 mL added) |
| 12 | C + Tr + Ag | 1 kg cement mortar + triclosan (concentration 0.0108 g/L, 0.5 mL added) + silver nanoparticles (concentration 100 mg/l.63 mL added) |
| 13 | C + GO + HClO+ Tr + Ag | 1 kg cement mortar + graphene oxide (concentration 4.5 g/l, 2.75 mL added) + hypochlorous acid (concentration 2000 ppm, 12.8 mL added) + triclosan (concentration 0.0108 g/L, 0.5 mL added) + silver nanoparticles (concentration 100 mg/l.63 mL added) |
| Lp. | Determination of the Sample | Contact Angle | Standard Deviation | Comments/Additional Remarks |
|---|---|---|---|---|
| 1 | C | 54 | 9 | The droplets persisted on the surface and were not absorbed by the grain structure of the centrifugal mortar. |
| 2 | C + GO | 41 | 6 | |
| 3 | C + HClO | 55 | 9 | |
| 4 | C + HClO* | 33 | 8 | After 1 min, all drops were absorbed and the contact angle was 0 deg. |
| 5 | C + Tr | 50 | 4 | The droplet stayed on the surface and was not absorbed by the grain structure of the centric mortar. |
| 6 | C + Ag | 56 | 11 | |
| 7 | C + GO + HClO | 82 | 20 | |
| 8 | C + GO + Tr | 10 | 1 | The droplet was gradually absorbed after application. After about 15 s, the contact angle was 1–2 deg and the surface was superhydrophilic |
| 9 | C + GO + Ag | 48 | 1 | The droplet was gradually absorbed after application. After approx. 15–20 s, the contact angle was 0 deg and the surface was superhydrophilic |
| 10 | C + HClO + Tr | 52 | 4 | The drops persisted on the surface and were not absorbed by the granular structure of the centre mortar. |
| 11 | C + HClO + Ag | 30 | 1 | The droplet was gradually absorbed after application. After approx. 40 s, the contact angle was 0 deg and the surface was superhydrophilic |
| Single-Point Bending | Compressive Strength | |||||||
|---|---|---|---|---|---|---|---|---|
| Oznaczenie Próbki | Breakload [kN] | Standard Deviation | Strenght [MPa] | Standard Deviation | Breakload [kN] | Standard Deviation | Strenght [MPa] | Standard Deviation |
| C | 0.66 | 0.02 | 1.73 | 0.05 | 3.70 | 0.01 | 2.30 | 0.01 |
| C + GO | 0.68 | 0.02 | 1.77 | 0.06 | 4.15 | 0.35 | 2.60 | 0.28 |
| C + HClO | 0.80 | 0.01 | 2.05 | 0.07 | 4.65 | 0.38 | 2.90 | 0.21 |
| C + HClO* | 0.53 | 0.03 | 1.43 | 0.06 | 2.93 | 0.50 | 1.83 | 0.31 |
| C + Tr | 0.68 | 0.07 | 1.75 | 0.17 | 3.80 | 0.17 | 2.37 | 0.06 |
| C + Ag | 0.63 | 0.07 | 1.63 | 0.21 | 4.25 | 0.21 | 2.70 | 0.14 |
| C + GO + HClO | 0.78 | 0.01 | 2.00 | 0.01 | 4.73 | 0.67 | 2.97 | 0.38 |
| C + GO +Tr | 0.57 | 0.01 | 1.45 | 0.07 | 4.30 | 0.14 | 2.70 | 0.14 |
| C + GO + Ag | 0.50 | 0.03 | 1.27 | 0.06 | 3.25 | 0.07 | 2.05 | 0.07 |
| C + HClO + Tr | 0.71 | 0.02 | 1.85 | 0.07 | 4.15 | 0.35 | 2.60 | 0.28 |
| C + HClO + Ag | 0.56 | 0.04 | 1.43 | 0.12 | 3.97 | 0.32 | 2.50 | 0.17 |
| C + Tr + Ag | 0.42 | 0.03 | 1.05 | 0.07 | 3.23 | 0.38 | 2.03 | 0.21 |
| C + GO + HClO+ Tr + Ag | 0.38 | 0.03 | 0.95 | 0.07 | 2.65 | 0.07 | 1.65 | 0.07 |
Disclaimer/Publisher’s Note: The statements, opinions and data contained in all publications are solely those of the individual author(s) and contributor(s) and not of MDPI and/or the editor(s). MDPI and/or the editor(s) disclaim responsibility for any injury to people or property resulting from any ideas, methods, instructions or products referred to in the content. |
© 2024 by the authors. Licensee MDPI, Basel, Switzerland. This article is an open access article distributed under the terms and conditions of the Creative Commons Attribution (CC BY) license (https://creativecommons.org/licenses/by/4.0/).
Share and Cite
Paciejewski, M.; Lange, A.; Jaworski, S.; Kutwin, M.; Bombalska, A.; Siwiński, J.; Olkowicz, K.; Mierczyk, J.; Narojczyk, K.; Bogdanowicz, Z.; et al. Effect of Doping Cement Mortar with Triclosan, Hypochlorous Acid, Silver Nanoparticles and Graphene Oxide on Its Mechanical and Biological Properties. Materials 2024, 17, 6288. https://doi.org/10.3390/ma17246288
Paciejewski M, Lange A, Jaworski S, Kutwin M, Bombalska A, Siwiński J, Olkowicz K, Mierczyk J, Narojczyk K, Bogdanowicz Z, et al. Effect of Doping Cement Mortar with Triclosan, Hypochlorous Acid, Silver Nanoparticles and Graphene Oxide on Its Mechanical and Biological Properties. Materials. 2024; 17(24):6288. https://doi.org/10.3390/ma17246288
Chicago/Turabian StylePaciejewski, Mikołaj, Agata Lange, Sławomir Jaworski, Marta Kutwin, Aneta Bombalska, Jarosław Siwiński, Klaudia Olkowicz, Jadwiga Mierczyk, Kamila Narojczyk, Zdzisław Bogdanowicz, and et al. 2024. "Effect of Doping Cement Mortar with Triclosan, Hypochlorous Acid, Silver Nanoparticles and Graphene Oxide on Its Mechanical and Biological Properties" Materials 17, no. 24: 6288. https://doi.org/10.3390/ma17246288
APA StylePaciejewski, M., Lange, A., Jaworski, S., Kutwin, M., Bombalska, A., Siwiński, J., Olkowicz, K., Mierczyk, J., Narojczyk, K., Bogdanowicz, Z., & Nasiłowska, B. (2024). Effect of Doping Cement Mortar with Triclosan, Hypochlorous Acid, Silver Nanoparticles and Graphene Oxide on Its Mechanical and Biological Properties. Materials, 17(24), 6288. https://doi.org/10.3390/ma17246288

